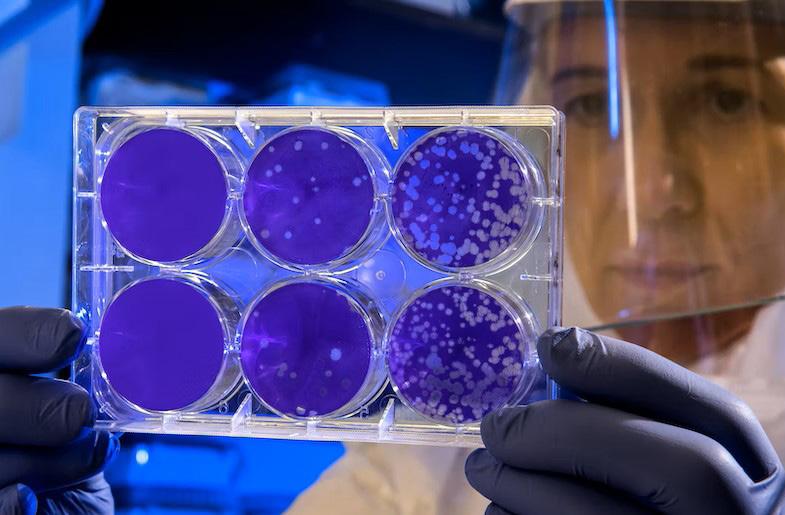

university for research


A LIVERPOOL care home has been helping Manchester University researchers looking at the future of care.
Oak Springs was one of four care homes to be approached by the University who wanted to interview a number of residents about what gives them a sense of purpose.
They also wanted to know to what extent they would like to engage in purposeful activities and the role of care staff in helping to achieve this.
Dr Laura Brown is a Senior Lecturer in Psychology at the University of Manchester, whose research focuses on cognition, health and wellbeing in later life.


She said: “I am interested in characterising the patterns of psychological functioning that are associated with ageing and in developing interventions to help improve health and wellbeing in older populations – particularly those in residential care home settings.”
The results of the survey showed that many residents experienced a loss of a sense of purpose when entering a care home and found it hard to make friends. Care home staff are seen as integral to fostering a ‘tailored approach’ to activities to help get it back.
“Purposeful activities tailored to the resident’s previous life work best,” added Laura.



“For example, a resident who was very good at sewing when she was younger would enjoy craft activities put on by an activity coordinator that encouraged that skill in others. This would help to create a sense of purpose for the resident.
“Research shows that residents who are given a ‘job’ in a care home, such as gardening or DIY, found that it can improve their quality of life. But it has to be built into the culture of the care home as an important part of people’s care.”
Andrea Lyon, registered manager of Oak Springs, which has created an initiative called ‘Project Busy’ to encourage residents to get involved in daily life activities, said:
“As part of our admission process our activities coordinators chat to each new resident and complete a ‘this is me’ document.
“This captures everything from their likes and dislikes to their hobbies and interests and really informs their personalised care plan.


“Our team encourages residents to complete little jobs if that’s what they would like to do.



“For example, a recent resident used to run her own sweet shop so we asked her if she would like to set up and help us run a tuck shop in the home. She loved it.
Laura’s research will be read in the UK as well as in America.
Agnes Kaye has become the oldest person to climb a 15-metre sycamore tree at a Thirsk activity centre. The 98-year-old outdoors-lover, who lives at Hambleton Grange, grew up on a farm in Kipling, Scotland, where she would ‘climb every tree in the area’ as a child. During her daily walk with the home’s care team, Agnes spoke of the joy she felt when she would get to the top of a tall tree in her youth, and expressed how much she wished she could climb a tree once again. Eager to fulfil her wish, the care team got in touch with Carlton Lodge Activity Centre, who were delighted to invite Agnes to take on their climbing tree challenge free of charge. After being lowered down on her harness, the team at Carlton Lodge presented Agnes with a certificate, naming her the ‘most spritely and mature person to climb this tree’.

Great night promised at CUK Awards
TICKETS are selling fast for the 2022 Caring UK Awards; with shortlisted care homes, sponsors and guests all looking forward to a great evening.





Organised by Script Media in partnership with Caring UK and headline sponsor Virgin Money, this annual celebration of success will culminate in a glittering ceremony – taking place at the Athena in Leicester on Thursday December 1 – where host Dean Andrews will reveal the lucky winners.






We received a record number of entries from all over the UK with so many stories of the wonderful work that is being done and we want to thank everyone who sent in nominations.
Shortlisted entries from far and wide have made the finals, now progressing to the next stage of the judging process.


Event organiser Dominic Musgrave added: “The standard of entries has been higher than we could ever have imagined, and we’re really looking forward to seeing everyone on the night.
“It was difficult enough for us to narrow the number of entries down into a shortlist so I don’t envy our judges who are going to have to choose the winners.

“The event itself will be a celebration of all that is good in the industry and the perfect party to start Christmas.”
Tickets to the industry’s party of the year are available at https:// script-events.co.uk/cuk-awardstickets

December 2022 no.311 Home teams
with
incorporating The Number One magazine for the care sector fallsavers.co.uk S DOC 12.85012B.12 Freephone: 0800 032 4789 Carpeted and Standard Floor Sensor Pads Available • Antibacterial • One-year warranty • Integrates with most nurse calls One monitor works with two sensor pads Floor Sensor Pads Wireless Options: • Call button • Pager • Floor sensor pad • Door/window exit alerts New Better Wireless Fall Monitoring Carpeted Standard
up
Totally Confidential No Obligation GRAYSON AND DAWN TAYLOR OVER 40 YEARS EXPERIENCE SELLING CARE HOMES NATIONWIDE LOOKING FOR A DISCREET SALE? Phone: 01937 842 758 m: 07920 475 440 SPECIALISING IN THE DISCREET SALE OF CARE HOMES, SPECIAL NEEDS HOMES AND SITES & DEVELOPMENTS FOR C2 USE NATIONWIDE COM LAMONT JOHNSON.


Experienced Nationwide Care Staff Care Assistants, Nurses and Care Managers www.bluerockcare.com info@bluerockcare.com To see how we can help call 0800 888 6165 Care Certificate and COVID-19 trained One fixed hourly rate whether day, night or weekend shifts Candidates available to start within 48 hours Flexible 3 - 12 month contract options Free temporary to permanent options Valid DBS checks and references Home Managers placed weekly *valid only on recruited candidates who have completed the Bluerock training course
Former neighbours tie the knot after reconnecting at home
CHURCH bells were ringing out for a pair of former neighbours after tying the knot at a Surrey care home – where they reconnected years later as residents.

Originally hailing from Farnham, Simon John Fisher and Tina Dawn Clark reconnected after moving into CHD Living’s Crest Lodge in Hindhead. Finding themselves living in close quarters for the second time in their lives, the duo, who previously lived just four doors down from one another, bonded through hours of late-night chats, organised activities and excursions — before Simon proposed on Christmas Day.
With the support of staff at Crest Lodge, the loved-up couple recently tied the knot at Guildford Register Office, following a heartfelt reception ceremony at the care home.
Shaleeza Hasham, head of hospitality and communications at CHD Living, said: “We are over the moon that we were able to provide Simon and Tina with their very own fairy-tale wedding.
“CHD Living is a family-owned and operated care provider, and whether at board level or within the homes amongst our residents, all staff get treated like family.

“On the day our family did us proud — from arranging the décor at Crest Lodge to organising the vintage Sunbeam Rapier car, every single detail of the wedding was considered and executed to perfection.”
“In particular, I would like to thank Krasi Petrova, home manager at Crest Lodge and Michelle Woodyatt, wellbeing co-ordinator at Kings Lodge, for their exceptional efforts in making this such a special and memorable day. We will never
forget the happiness brought to two of our residents, and are delighted to think we played a role in their ‘happily ever after’.”
Simon and Tina selected Crest Lodge wellbeing coordinator Christopher Edwards to be their best man. And fellow wellbeing coordinator Donna Paul and home manager Krasi Petrova, were chosen as witnesses to the couple’s matrimony.
www.caringuk.co.uk

Advertising Healthcare Product Manager: Bev Green Tel: 01226 734288

bg@scriptmediagroup.co.uk
Assistant Sales Manager: Tracy Stacey Tel: 01226 734480 caringuk1@scriptmediagroup. co.uk
Sales and Marketing Director: Tony Barry Tel: 01226 734605 tb@scriptmediagroup.co.uk
Publishers


Script Media
47 Church Street, Barnsley, South Yorkshire S70 2AS. info@caring-uk.co.uk
Editorial Publishing Manager: Dominic Musgrave Tel: 01226 734407 dm@scriptmediagroup.co.uk

Studio Manager: Paul Hopkinson Tel: 01226 734711 ph@scriptmediagroup.co.uk Database enquiries to: 01226 734695 circulation@ scriptmediagroup.co.uk
Whilst every effort is made to ensure the accuracy of all content, the publishers do not accept liability for error, printed or otherwise, that may occur.



Follow us on Twitter @caringuk




www.electronicmar.co.uk




3 CARINGNEWS At Script Media, we try to get things right but occasionally, we make mistakes. If you have a complaint about a story featured in our magazine or on our website, please, in the first instance, contact us by email: dm@scriptmedia.co.uk We abide by the Editors’ Code of Practice as demanded by the Independent Press Standards Organisation. For details on the code and what to do should you be unsatisfied with the way we handle your complaint, please visit www.ipso.co.uk Training included Electronic MAR / Medication Recording Used by 1000’s of care professionals to ensure complete records
“More time with residents and less time on paperwork” Call: 0117 911 3889 Web: www.electronicmar.co.uk Email: good@electronicmar.co.uk Contact us now for a FREE quotation and 20 minute product demonstration Less time with paperwork = more time to care Real-time Alerts = no gaps Ensure your evidence is complete for CQC Automatic Stock Notification 96% of our customers have a Good rating or better 22% of customers have improved from a Requires Improvement rating to Good Good Outstanding
Residents enjoy their own show thanks to Hospital Radio Perth
BALHOUSIE Care Group residents in Perthshire have their own radio show thanks to a partnership with Hospital Radio Perth.

The award-winning station, based at Perth Royal Infirmary, has launched weekly request shows aimed at 12 Perth and Kinross Balhousie Care Group homes.
Residents will be able to select their favourite music and hear it broadcast on the station especially for them.
The programmes will be presented by experienced broadcaster Peter Hay, who went along to Balhousie North
Inch care home to launch the service.








He told the residents how this development was something the station had wanted to do for some time, but recent technical developments had, at last, made it possible.
Diane Cain, home manager at Balhousie North Inch, said: “Meaningful, stimulating and individualised activities are a crucial part of our care at Balhousie, as are community partnerships, and you don’t get any better than your own local radio show.”

Amanda awarded prestigious title of Queen’s Nurse


CANFORD Healthcare’s quality and compliance manager Amanda Rae has been awarded the title of Queen’s Nurse by the Queen’s Nursing Institute.
Amanda is the second senior manager within the group to have been awarded the prestigious title following operations manager Caron Sanders-Crook last year.
Amanda is now entitled to use the title of Queen’s Nurse in recognition of her outstanding contribution to nursing over the last 27 years.
“Becoming a Queen’s Nurse is an amazing honour in recognition of my contribution to nursing,” she said.
“I am so pleased and proud to have been recognised. I also feel honoured to be a part of such an inspiring and innovative community.”
Amanda started her career in health and social care at the age of 14.
Having been inspired by her grandmother’s experiences as a carer during the war, she began visiting an elderly lady after school to keep her company – and quickly realised that the care sector was where she wanted to be.
She became a carer after leaving school, then trained as a registered general nurse. After qualifying in 1995 she worked in a hospital setting on several acute medical wards before social care called her back.
Alongside gaining her Levels 5 and 7 in Business Studies and a postgraduate diploma in Human Resources, Amanda has worked in a variety of roles, both out in the community and in residential/ nursing care, from care assistant through to senior sister, HR and training manager, registered manager and operations manager.
“I am passionate about great care and doing the right thing for the right reasons,” she added.









“My approach is to lead by example and never ask anyone to do anything that I am not prepared to do myself.
“I feel that there are very rarely bad people, but there may be a bad policy, process or procedure that needs review.



“With every problem there is room for a solution, and with every challenge there is an opportunity waiting to be taken.
“To me, it’s an honour and a privilege to assist people – in their own home or in residential/nursing care – to live their best life in their preferred way.”
Her current role involves setting and monitoring standards to ensure that the organisation meets its regulatory obligations.


During the pandemic, Amanda was not able to visit Canford Healthcare’s 11 homes as often or as regularly so, without any IT training or expertise, she single-handedly built an online governance system, using Microsoft 365.
This performs many crucial functions such as planning, bespoke audits, identifying trends and issues, discovering training needs, storing core information, communicating with the homes and providing news alerts.

Within Canford Healthcare, the process is referred to as the Governance and Quality Cycle, which facilitates safe, person-centred care and the best resident outcomes.
The system has been a finalist in several industry award schemes and recognised as business leading by external professionals.




Amanda has demonstrated it within Care England forums and is supporting other organisations within the sector to implement their own version of it. She has also fed back suggestions for improvement to Microsoft itself.
Village to become ‘drop off’ point



CHILDREN in Gloucestershire will receive advent calendars through local charities, courtesy of Richmond Villages Painswick and Richmond Villages Cheltenham.

sell your business. We have actually already recommended them to some other Care Home owners. We wish you both the very best in the future. Many thanks Mr. R and Mrs. G Rai
The retirement villages will be partnering with children’s charities such as Pied Piper Appeal, James Hopkins Trust and Young Gloucestershire and are appealing for Christmas advent calendar donations.
Both the Pied Piper Appeal and James Hopkins Trust provide care for children with life-limiting illnesses and support for young people and their families, whilst Young Gloucestershire helps disadvantaged
young people who are facing challenges in their lives.
Painswick Village manager Matt Evans said “Giving back to our community is a big priority for Richmond Villages and we are always looking for different ways we can support charities and their causes.
“This year we want to act as a donation point to try and bring the whole community together to support these amazing children and, all the staff who work tirelessly to provide the best care possible.”
The village will be a drop-off point for donations to help and support young children and their families.

CARINGNEWS 4 LAMONT JOHNSON TO THE CARE SECTOR PROPERTY ADVISORS JohnsonLamont m.07920 475 440 01937 842 758 PHONE GRAYSON or DAWN TAYLOR TODAY LOOKING FOR A DISCREET SALE? lamontjohnson.com Office@lamontjohnson.com Our success in the sale of Care Homes is second to none in the care sector, and has been achieved through the 41 years experience of principal directors, Grayson and Dawn Taylor, specialising solely in the discreet sale of Care Homes and sites/developments for C2 use nationwide. COMPLETES ANOTHER CARE HOME SALE IN STAFFORDSHIRE KINGSLEY COTTAGE CANNOCK STAFFORDSHIRE SOLD NO “UPFRONT” FEES KINGSLEY COTTAGE 40 UXBRIDGE STREET, HEDNESFORD, STAFFORDSHIRE, WS12 1DB TELEPHONE 01543 422763 Lamont Johnson Property Advisors to the Care Sector Dear Grayson and Dawn It had been a di cult decision to sell Kingsley Cottage, a er over twenty years of ownership. We would like to thank Grayson and Dawn for all their expertise and help in completing the sale of Kingsley Cottage. We did make the mistake of being seduced by a national sales agent, with great promises that turned out to be very hollow. All they did was take our money. Grayson on the other hand was very down to earth and forthright, telling us how it was. Also having no upfront fee reassured us that they were not in it for a quick payday. e sales journey was by no means easy, but Grayson and Dawn were always available for dialogue, to help and advise. e recommendations on the way were excellent, our solicitors were very good, helping in directing purchasers to nance options was a big help. Con dentiality of the sale was a major point, us being a small home, which was handled very well. Overall, we would recommend Grayson and Dawn if you are looking for an agent to
lamontjohnson.com SELLING NATIONWIDE FOR OVER 40 YEARS Dawn Taylor, Director, Lamont Johnson Ltd and Mr Ruggy Rai, owner of Kingsley Cottage. Kingsley Cottage Care Home had been in existing ownership for over 20 years, with an overall CQC rating of “Good,” and has been purchased by the West Midlands based, first time buyer, Dr and Mrs Sukhcharan Singh.
Amanda Rae
What Makes a Care Business Successful?
Is it because of a ‘good’ or ‘outstanding’ rating from CQC? Is it because of high occupancy or high weekly hours? Or maybe it’s due to a healthy staff culture?
Most people who have run or managed a care business know that any one of these components by itself isn’t the answer.
You’ll understand that all the different parts of a care business such as compliance, care delivery, HR, marketing and finance, must function together seamlessly, to create success and balance for the long-term. The Care Ideals team have been in your shoes and know it as well.
We’ll work with you to achieve balance and growth in all areas. Our support will help create a care business that delivers exceptional care, is operationally sound and also profitable.
Our unique and innovative One Stop Shop approach simultaneously addresses every aspect of your care business. It saves you time and makes your life easier, as you only have to deal with one supplier for all these many needs.
Whether you’re the owner of a care home or nursing home, a domiciliary care provider, a supported living provider, a registered manager, or a care franchisee, we work as your business partners and advisers, providing a tailored level of on-going business, operational and staff support. This ensures that your business is managed successfully, leaving you and your team to deliver exceptional care.
All these benefits, all from one place and all the time!
We offer three different levels of support and we’re happy to discuss which will be most suitable for your specific requirements.
“It is a pleasure to work with David. He is probably one of the most hardworking people that I have met and I am confident he would be an asset to anyone who makes use of his consultancy services. I saw engaging David as a Business Consultant as an investment which for us has been hugely rewarding.”
“I have once again seen how David balances the many pressures and conflicting priorities that come with running a business. David continues to ensure he has all the information he needs prior to recommending considered and sustainable changes, so as to address quality and financial issues to his clients. He has the experience to skilfully balance the needs of residents and patients, the staff and the shareholders and owners”
“As well as the operational improvements that David has been involved in, he has helped to give the business the impetus required to move forward. David is committed to helping people achieve their full potential and his focus on quality client care is completely genuine.”
Please contact us to discuss how our One Stop Shop can help you. 0330 133 5720 | enquiries@careideals.com | www.careideals.com
The Care Ideals One Stop Shop provides support in all aspects of your care business.
Providing the balance between good business and exceptional care
Residents gift shoeboxes for disadvantaged children
RESIDENTS from Colten Care homes have filled more than 100 shoeboxes with gifts for disadvantaged babies and children in Ukraine and Romania this Christmas.

The boxes, which have been packed with soft toys, stationery, warm gloves and mittens, books and toiletries, were handed over to the Rotary Club of Boscombe and Southbourne, which is collecting shoeboxes across the district for distribution to Eastern Europe.
Colten Care’s senior companionship team leader Donia O’Connor said: “We are very proud at Colten Care to have a long-standing relationship with the Rotary and this wonderful scheme.
“For me personally it’s always deeply inspiring to stand amongst all the festive shoeboxes that our residents have lovingly packed, knowing they will soon be opened by children who have so little.”
Homes which have provided shoeboxes this year were Avon Cliff in Bournemouth, Fernhill in Longham, Brook View and Amberwood House in Ferndown, Kingfishers in New Milton, Linden House, Belmore Lodge and Court Lodge in Lymington, Whitecliffe House in Blandford Forum, Abbey View in Sherborne, Newstone House in Sturminster Newton, St Catherines View and Abbotts View in Winchester and Canford Chase, The Aldbury and Bourne View in Poole.
Boscombe and Southbourne Rotarians David Shires, Leon Warner and Neal Curtis collected all the boxes from Bourne View in Poole.
Zoe Rose, companionship team leader at Bourne View added: “We love being the central point to which all the Colten Care shoeboxes come. Seeing them all here, prepared with such love and care is wonderful and we feel privileged to be part of it all.”
Operator addresses cost of living crisis
NATIONAL care home provider Renaissance Care is addressing the ongoing cost of living and energy crisis by introducing a series of energy saving measures, including solar panel installations and sensor lighting.

The changes, which are being implemented across the group’s 16 residential care homes throughout Scotland, will also cut the group’s carbon emissions.

Robert Kilgour, executive chairman of Renaissance Care, said: “It’s pertinent to the futureproofing of our facilities that we take steps to curb the soaring cost of energy and while we cannot stave off the effects completely, we can take steps to improve our energy efficiency in each of the homes and take simple steps to save where we can.
“The measures we are introducing will also reduce our carbon emissions and help us take action against climate change.
“In addition to the steps that we have already taken, and are planning to take, we are also engaging two renewables consultants to survey our homes and make recommendations on how we can further strengthen our energy saving efforts.”


Among the key measures being implemented are the full switching over to LED lighting, which is 75 per cent more efficient than incandescent lighting, and the adopting of motion
sensor lighting systems which means lights will turn off when rooms are no longer in use.

There has already been significant investment in energy efficient boilers, which are now installed in 85 per cent of the homes, and an upgraded insulation programme has also been carried out throughout all of the operator’s facilities.
Additionally, the group is planning to install solar panels on to most of the care homes to generate energy as well as an upgrade to several of our heating systems to include radiant panels.
The current and proposed changes are predicted to save the homes in the Renaissance Care group significant energy costs.
CARINGNEWS 6 WANT TO TRY? Call 0800 086 2496 Find out more www.c-t.co.uk
Robert Kilgour

Forbes Professional forbespro.co.uk | 0345 070 2335 | info@forbes-professional.co.uk | since 1926
Sky’s the limit as Roger completes wish to fly
A CARE home resident in Basingstoke has completed a lifelong wish.
Roger Mashall, a resident at Care UK’s Dashwood Manor, took to the skies and had his first flying lesson.

When Dashwood Manor first opened in September 2021, the team installed a ‘Wishing Tree’, an initiative launched which allows residents to suggest ideas for new hobbies they’d like to try, places they’d like to visit or even activities linked to past careers.
This encourages residents to live fulfilling lives – from skiing to a fish and chip supper, no wish is too big or small.
After his friend and fellow resident, Dennis Moulton, jumped out a plane at 15,000 feet for charity earlier this year, Roger was inspired to complete his life-long dream which was to fly a plane.
Home manager Dil Perera said: “No wish is too big or too small and so when Roger said he wanted to fly a plane we knew we had to make his dream a reality.
“We are thrilled to have helped Roger complete his lifelong wish and it was wonderful to see the smile on his face as he landed after his flight.
“The team has organised many wishes for residents in the past 12 months including the skydive for Dennis, a tattoo for Helen, a resident who wished for a tabby cat tattoo, and now a flying lesson for Roger. I am very proud of the team who
consistently go above and beyond to make resident wishes come true.
“I cannot wait to see what wish we organise next – the sky really is the limit.”
Roger has always had an interest in aircrafts. He joined the army as an apprentice in 1956, where he worked as a mechanic and was then sent to a regiment to fix a variety of small, armoured reconnaissance vehicles.
He was called in to work on aircrafts for a short time, but didn’t find the experience to be what he imagined, so returned to his original trade. Though he was happy in his job, he occasionally thought about what may have been and had a yearning for aircrafts.
Using a connection he had, Roger finally flew as a passenger in a light aircraft in the 70s. He took in the views of Seattle and described the trip as a once in a lifetime experience. The trip made Roger even more eager to learn to fly a plane himself.
After he moved into Dashwood Manor, Roger was not sure if his dream would ever become a reality, but once he saw the teams’ efforts to make his friend Dennis’ wish come true. He was inspired to put his wish on the wishing tree.
The team wasted no time getting the wish off the ground and soon the day came for the flight. Roger took to the skies for a lunchtime flight after some training on the ground at Blackbushe Airport, Camberley.
Outstanding employees recognised at ceremony
OUTSTANDING employees at Hallmark Care Home were recognised at an annual awards ceremony.
The event, held at The Renaissance London Heathrow Hotel, was jointly hosted by executive chairman Avnish Goyal CBE, managing director Aneurin Brown and stand-up comedian Angela Barnes.
Aneurin said: “The Hallmark Awards are a great opportunity to celebrate with the team members who have demonstrated our values and that of our Charter. It felt great to recognise
those particular team members who go above and beyond and are outstanding in their roles.”
Team members were recognised for going above and beyond in their care provision at an evening event followed by entertainment from The Function Band.
Each winner had been nominated by residents, relatives, colleagues, and senior Hallmark executives.
The big winner on the night was Ty Enfys Care Home in Cardiff who scooped Care Home of the Year.
Staff experience firsthand what it feels like to be a resident
STAFF at RMBI Care Co. homes recently took part in an innovative training programme called Experiential Learning to mark Alzheimer’s Day.
Through this training, staff have the opportunity to experience first-hand what it might feel like to be a resident in a care home.
One of the sessions took place at Prince George Duke of Kent Court in Chislehurst.
Staff members were presented with different challenges, such as wearing a wet incontinence pad throughout the training session, doing a crossword while wearing goggles that simulate impaired vision, and wearing gloves to simulate arthritis.
The aim was to help give them a better understanding of how residents should be cared for, and develop a greater sense of empathy in their roles.
Training manager Maisie Bourne said: “All staff at our home at every level have to go through this training.
“It’s important that we all understand the challenges faced by our residents, whether they have a mobility need, require support at
mealtimes or need additional one to one support.”
As part of the training session, staff members also took part in a variety of scenarios, such as:
n Being pushed in a wheelchair with artificially impaired vision.
n Being supported to eat a meal by another trainee.
n Having their face and neck washed by another trainee.
n Being left on their own in an empty room whilst unable to move from their chair.
The programme was first launched in 2014 and has been refined and expanded with different scenarios in recent years.
Louise Bateman, group human resources director at RMBI Care Co., added: “Learning through experience can be very powerful; this programme has become a vital tool in supporting new staff members to empathise with residents and to care with compassion.
“We want to ensure that we recruit individuals not solely upon their technical skills or abilities, but on the basis of their values and attitudes to care.”
Residents raise funds for hospice care in Somerset
CAMELOT House and Lodge in Wellington has contributed more than £130 to the nearby hospice’s autumn fundraising campaign after a ‘Wear it Yellow’ day that saw the care home drenched in sunshine colours and a range of fun money-making activities laid on.
The activities team brainstormed ways to embrace the yellow theme and started off by decorating throughout with bunting, helium balloons and pictures of sunflowers.
Progressing the colourful theme, staff and residents donned outfits in sunny colours, including an eye-catching banana-suit that was sported by activities co-ordinator Richard Dempslake.
He said: “We organised two distinct
activities, giving residents a choice between doing arts and crafts –painting or using chalks on templates of sunflowers – or decorating cakes with a vibrant lemon buttercream.

“We always try to include some musical interest so we did a special playlist for the day. Most of the fundraising was done through a bake sale, with a huge range of cakes contributed by staff, families and friends, and we also collected donations from those who wanted to take part. St Margaret’s Hospice does amazing work for people in Somerset who need end-of-life care and we were pleased to make a contribution to support them.”
The seasonal fundraising target for St Margaret’s is £10,000.
CARINGNEWS 8
Resident Judith Ashcroft with the yellow-themed buffet and decorated lounge.



Caring UK, the UK’s number one magazine for the care sector, now has a new website.





Packed with news, features and information, the Caring UK website provides a central hub for anyone who works within the UK sector to keep up-to-date with all the latest developments in care.
The new site delivers more content, news features and information, and is the one-stop site for everything related to care in the UK.

us
Visit
today at www.caringuk.co.uk
Government care recruitment drive
‘won’t tackle crisis’
A GOVERNMENT recruitment drive for adult social care is welcome but is merely an attempt to patch up the sector rather than tackle the underlying crisis, campaigners have warned.
The Department of Health and Social Care recently launched its annual recruitment drive to encourage people into a career in social care.


Whilst welcoming the move, care provider organisation,The Independent Care Group warned it would not tackle the elephant in the room which is the poor pay of the social care workforce.
Chair Mike Padgham said: “Anything that helps us tackle the shortage in social care staff is welcome.
“But it won’t tackle the underlying cause of the 165,000 vacancies in social care, which is a shortage of funding that goes back more than 30 years.
“And it is disingenuous of the Government to lay the blame for poor staff pay at the feet of providers when its chronic and relentless underfunding of social care has made it impossible for those providers to afford to pay staff much above the National Living/Minimum Wage, however much they want to. They must be able to pay staff at least on a par with the NHS.
“The Government must address the poor pay of the social care workforce by reforming and properly funding the sector. It can start by injecting the minimum of £7bn extra a year into social care the Chancellor has previously said was needed.
“Then maybe we will be able to properly pay those working in social care and make it a profession people will want to join rather than going to work in a supermarket or online shopping warehouse.
“Efforts like this are sticking plasters when this, as William Beveridge said in 1942, is “a time for revolutions, not
for patching”.

The ICG is concerned as the crisis in social care deepens and providers warn repeatedly that the sector is in danger.


A financial impact assessment, commissioned by members of the CQC Market Oversight Scheme, recently warned that care providers fear the sector is on the brink of collapse.
Mike added: “Here we see yet another terrifying report, from the Government’s own care watchdog, warning of the imminent collapse of the social care sector because of the dire financial state it is in.
“At the moment the sector is suffering death by a thousand cuts because it is seeing smaller care and nursing homes and home care providers closing and handing back contracts.
“But it can only be a matter of time before we see a big provider close with the same frightening impact the collapse of Southern Cross had back in 2011.
“Maybe then the Government will take some action. My fear is that they won’t and it will only be when the loss of social care provision brings hospitals to an absolute standstill that ministers will wake up to the crisis on their doorstep.”
The ICG says more than 30 years of neglect and under-funding has left social care on the brink of collapse, with Covid-19, chronic staff shortages and the cost-of-living crisis turning the situation critical.
Care and nursing homes are closing and homecare providers are handing back undeliverable contracts.
At least 1.6m people are living without the care they need and there are 165,000 job vacancies in the sector.
It has written to the Prime Minister and the Chancellor calling upon them to give social care at least an extra £7bn a year.
Bras in bloom for breast cancer research funds
BRAS were blooming on trees inside and outside of The Hillings care home in St Neots to raise awareness about breast cancer.
October was Breast Cancer Awareness month and all funds raised go to research into causes, treatment and education about breast cancer.
Home manager Tracey Morris, who was diagnosed with breast cancer herself in 2018, said: “This is a cause which is close to my heart and it was fantastic that residents, relatives and

staff all wanted to get involved.
“We had unwanted bras donated by relatives and the residents decorated a tree inside and outside the home, we held a wear it pink day and staff made donations for the privilege of wearing pink for the day, we made pink ribbons to sell, everyone got involved.

“I want to say a big thank you to everyone who donated or was involved in any way, we have raised more than £120 already.”
Alzheimer’s Dementia
11 CARINGNEWS
FOR PEOPLE WHO CARE
and
tickets visit www.alzheimersshow.co.uk 3 4 MARCH 2023 BUSINESS DESIGN CENTRE, ISLINGTON, LONDON for CARE PROVIDERS • HEALTH & SOCIAL CARE PROFESSIONALS • FAMILY CARERS THE ALZHEIME R’S DEMENTI A & CARE SHOW YEARS 2013 - 2023 VIRTUAL DEMENTIA TOUR 1-2-1 CLINICS LATEST PRODUCTS & SERVICES EXPERT SPEAKERS SUPPORT & ADVICE supported by accredited by in partnership with
If you’re involved in caring for others, the
& Care Show is for you. Now in its 10th year the event features a CPD accredited speaker programme, wide range of care exhibitors, experiences and training you won’t find anywhere else, and provides a great opportunity to learn, discover new solutions, and further your professional skills.
For more information
to book
Bluebird Care Winchester, Eastleigh and Romsey has extended its support to a local school’s girls football team ahead of the new season – stepping in to provide new kits. The home care provider has sponsored the year five and six girls football teams at Oliver’s Battery Primary School in Winchester. The support from Bluebird Care Winchester, Eastleigh & Romsey carries even more significance, with the team previ ously having no kits and having to make do with unmatching polo shirts and PE kits. However, with the help of the home care provider, the girls will now take to the pitch in full kits that proudly adorn the school’s crest and squad numbers.

AAT takes steps to address delay in delivery of adaptations
ADAPTATIONS deliverers are being given new steps to expediate solutions and minimise risk for clients needing support with a new initiative from AAT GB.
The company, better known as the stairclimber people, has invested in a significant increase in its stockholding capability for its number one selling S-Max stairclimber.
As a result, the machine can be delivered to the client within three working days of receipt of order (subject to T&Cs), compared to the weeks or months currently offered by alternative inter-floor transfer options.
Dealing with stairs is one of the four most common requirements for adaptations and causes for delay in hospital discharge.
Minimising the risk of inter-floor transfer is therefore a major priority for anyone involved in delivery of adaptations.
Utilisation of a stairclimber minimises that risk, without any of the disruption to the household of moving beds downstairs, impeding stair access for others etc.
The S-Max is proven to be a viable solution in almost all stair configurations, and has an impeccable safety record. It can be used by almost any carer; AAT provides full training as part of the supply package.
“An S-Max stairclimber, is a quick, costeffective answer to dealing with the growing backlog of adaptations: almost all local authorities have at least one on their books, which can be re-issued for less than £1000,” said AAT director Peter Wingrave.

“By investing in our stockholding we are further committing to support the sector in addressing the backlog, enabling us to deliver a new stairclimber to the client within three working days of order, if there is not one available in stores.
“Even if provided as a short-term solution whilst a more permanent fixture is achieved, it offers OTs, trusted assessors et al to minimise risk incredibly quickly, and give client a safe, easy to use option to access all levels of their home, and beyond into the garden or wider community, in almost all stair scenarios.”
Enquiries: Full details of the S-Max stairclimber and an form can be found at https://www.aatgb.com/s-max/
Balhousie Stormont kicks off new sponsorship deal
BALHOUSIE is getting onside with Blairgowrie Junior Football Club following a new sponsorship deal.
The group and its Stormont Lodge care home in Blairgowrie is funding the kit for the Blair Junior League team in the latest in a series of community partnerships for the award-winning group.
“We are committed to real community involvement for our residents and our staff,” said home manager Jules Ritchie-Urry.
“Our philosophy at Balhousie Care
Advertiser’s announcement
Group is that care homes are a vital and active part of the community, which is why we are delighted to support Blairgowrie Junior Football Club.”
The sponsorship of Blair Junior FC marks the latest in several new partnerships this year for the care group, which operates 26 care facilities in six regions of Scotland.

Other sponsorships include backing blind golfer Barry McCluskey, Arbroath Bowling Club and Crieff Highland Gathering.
Care home essentials that prioritise people, planet and your pocket
EDDY Fishwick, chairman of CareHomeLife, and his team of friendly experts are challenging and changing the way care homes buy their consumables and equipment. It’s a big promise, but one they’re confident they can keep.

CareHomeLife, a family run business, has been committed to this brilliant sector for more than 40 years.
They work hard to understand the challenges facing all those working in care homes and crucially the unique pressures facing carers, staff and management today.
They also know it’s simply not enough to be a ‘supplier’.
They have committed to going much further, to actively support care homes to get the most from their budgets and helping them to provide the very best care to residents.
CareHomeLife’s friendly experts show care homes how to:
n Use fewer consumable products.
n Get better cleaning results – first time.
n Maximise infection control.
n Create less waste.
n Save staff valuable time
n Reduce environmental impact.
n Cut operating costs.
n Create safer, healthier environments.
In short, they make it possible for care homes to do so much more, with much less.
People: Care homes are safe in their expert hands
CareHomeLife has a trusted reputation for industry-leading service.
Their well-stocked warehouse includes worldclass medical healthcare supplies, cleaning, housekeeping, laundry, incontinence care and medical equipment.
More than 98 per cent of stock orders reach care homes complete and on-schedule.
Though what sets them apart is their talented, knowledgeable team who put care home customers’ satisfaction above all else, united by their dedication to Honour our loved ones with dignity.
Planet: Together we can achieve more and use less They rigorously select their manufacturing partners
based on alignment with their values, which include product quality, availability, suitability, and sustainability.
They also share passion for the environment and the care sector, with clear sustainability objectives that align with their own.
Together we can minimise the environmental impact at every phase of the product lifecycle.
Pocket: Helping care homes to do more with better less CareHomeLife focus on the ‘Total Operating Value’ of care home essentials.
That is, realising long-term, sustainable savings by using quality products and improving processes.
True value for care homes comes from being able to do more with less.
Using fewer, but better-quality products that save staff valuable time and energy, without compromising results and safety.
Visit carehomelife.co.uk or book a free review by emailing info@carehomelife.co.uk or calling 01772 425310.

CARINGNEWS 13
Jules Ritchie-Urry with players Lawrie Mitchell and James Simpson.






NEW Ultra Laundry range Ultra Laundry Liquid • Concentrated formula • Suitable for manual and auto dosing • Plant based, biodegradable stain removers • 7 days lasting freshness • Tough on stains even at 30°C washes Ultra Fabric Conditioner • Concentrated formula • Suitable for manual and auto dosing • Helps lock in colours • Long lasting fragrance bursts MORE ONLINE WWW.GOMPELS.CO.UK specialist wholesale supplier to 1000s of UK care homes Please see website for latest prices Prices correct as of 1st October 2022. E&OE *Top 250 core lines 100% in stock as of 11/10/2022 VINYL GLOVES NOW EVEN LOWER 100% IN STOCK* Vinyl Gloves £2.19 per 100 gloves Ultra Laundry Liquid £24 per 10 litres 41851 Ultra Fabric Conditioner £11.50 per 10 litres 65944 With our easy to use tools and get control of your purchasing Spend 25% less Get a quick overview of annual spend from your Business Dashboard, the figures are updated with every new order placed. gompels.co.uk/dashboard Set Budget Management for every site Expenditure alerts gompels.co.uk/alerts Set up budget management Alerts that send you an email when expenditure is approaching or has exceeded its limit. Find out more at www.gompels.co.uk/tools Centralise purchasing by removing products you don’t want your sites to buy, reduce spend on products and increase your profits! See full range at www.gompels.co.uk/laundry

St Mellion International Hotel 1 March Bristol - Aztec Hotel & Spa 2nd March Durham-Ramside Hall 16th May Blackpool Village Hotel 17th May Barnsley - Holiday Inn 13th July York Racecourse 6th September Ashford International Hotel 24th October Norwich Dunston Hall 25th October DATES FOR YOUR DIARY C ARING UK CONFERENCES 2023 Join us for an informative day meeting care suppliers, industry experts and like minded care professionals EARLY BIRD SPECIAL OFFER Book now - £20 single delegate, £30 two delegates All delegates receive lunch, refreshments, a goody bag and a 6 hour CPD attendance certificate Tel: 01226 734412 www.caringukconferences.co.uk Email: cr@scriptmediagroup.co.uk C ARING UK CONFERENCES 2023
C ARING UK CONFERENCES
South West St Mellion International Resort PL12 6SD
South West Aztec Hotel & Spa BS32 4TS
North East Ramside Hall, Durham DH1 1TD
North West Village Hotel, Blackpool FY3 8LL
Wednesday 1st March 2023
Thursday 2nd March 202
Tuesday 16th May 2023
Thursday 17th May 2023
Yorkshire Holiday Inn Barnsley (M1, Junction 37) S75 3JT Thursday 13th July 2023
Yorkshire York Racecourse YO23 1EX
Wednesday 6th September 2023
East Midlands Dunston Hall Hotel, Norwich NR14 8PQ
Ashford International Hotel & Spa TN24 8UX
East of England
Tuesday 24th October 2023
Wednesday 25th October 2023
BOOKING CONDITIONS
All places booked must be paid within 15 days of booking and before the conference unless otherwise agreed with Script Events. A telephone or fax booking must confirm when and how payment will be made
A refund will be given, less £20 admin, fee for cancellations received more than 15 days prior to the conference. No refunds will be given with less than 15 days to the conference. However, delegate substitutes will be accepted to the day of the event at no extra cost.
Where invoices are requested and agreed, payment must be received within 15 days from the invoice date. We understand and will exercise out statutory rights to claim interest and compensation for the debt recovery costs under the late payment legislation if we are not paid according to agreed credit terms. An interest rate of 8% above base rate will apply for late payment.
Script Media Group is committed to protecting your personal data. By attending our events, we provide you with an opportunity to meet and engage with our exhibitors. Our events create business to business relationships and give access to relevant industry people, products and services.
We share your business information with the exhibitors and speakers so that they can review the companies that have attended today’s event, we DO NOT share personal information without your consent.
Please tick to receive a regular copy of Caring UK Please tick to receive information from exhibitors
Caring
FORM
BOOKING
Please sign and date here to indicate you have read and accept the booking conditions: Signature............................................................. Date:.......................................... Payment Method I enclose a cheque payable to Script Events. Invoice me.
my credit/debit details. Ms/Mr/Mrs/Dr................................................................... Position....................................................................................... Organisation................................................................................................................... Address........................................................................................................................ ................................................................................................................................... Post code.......................................... Email......................................................................................................... Tel....................................................................... Title Name Surname Job Title
The Road to Success Single delegate rate £20 per person Two delegates £30 Event attending: Delegates attending (Please print in block capitals) Booked By:
Phone for
UK Conferences, Script Media Group Ltd, 47 Church Street, Barnsley, South Yorkshire, S70 2AS Tel:01226 734412 Fax: 01226 734478
2023
NHS proven disinfection system
THE Glosair is a simple machine which has been relied upon for over a decade by the NHS, to preventatively, or reactively, disinfect rooms up-to 2,000m3.
Building on that reliability, WASSENBURG Medical are proud to launch the new WASSENBURG Glosair®, which has been developed and improved in every way, and is now the ideal solution for managing Infection Prevention and Control in Care Home’s, too.

The new WASSENBURG Glosair® is a robust, fully self-contained machine which uses patented technology to disperse an environmentally friendly, biodegradable dry mist into the atmosphere; safely, effectively and economically eliminating all viruses, bacteria, fungi, yeasts, and spores.
The odourless dry mist (Hydrogen
Peroxide Vapour) contains only 6% Hydrogen Peroxide, and Silver, eliminating COVID, C-DIFF and MRSA whilst achieving up to a LOG 6 reduction, with no residue, corrosion, allergens, or toxins.



We understand that protecting your residents, staff and visitors is your number one priority and that you want to be able to do this this as safely, reliably, and effectively as possible. The features and benefits of the WASSENBURG Glosair® support you in doing this.
It’s safe; uses RFID technology, securely and safely locking the chemical cartridges in place. Is manufactured to IS0 13485, despite not being a medical device. Comes with a remote control for added convenience and reassurance. Is an all-in-one, ‘1-plug’ system,
minimising set-up and trip hazards. Has a simple appearance and is easy to use, empowering staff without making residents nervous.
It’s effective; with proven, validated efficacy conforming to EN17272. Provides 100% aerial and disinfection of all exposed surfaces, including even complex and out of reach areas. Is compatible with NHS encrypted USB’s, for recoverability and traceability of up to 200 treatments. Has optional testing kits, proving dispersion and efficacy, for accountability.
It’s efficient; 1 system, for most rooms. Is a whole room disinfection system, doesn’t tie-up staff. Has patented dispersion technology, for perfectly uniform dry mist coverage. Has an integrated fan, speeding up diffusion and degradation of the
chemical. Is pre-programmable with up-to 20 rooms, taking seconds, saving hours. Is fully automated, ‘set-and-forget’, enabling staff to carry on working. Has 3 rubber castors, quick and easy to position in tight side-rooms. Has a 5m power cord, for convenience. Has a strong commercial grade body and handle, saving damage repair time.
It’s economical; incredibly good value for money compared to competitors, and uses only 1-7ml/ m³ flexible flow rate of chemical, resulting in zero waste and low ongoing running costs...
Why not give me a quick call now? And we can arrange a mutually convenient time for an on-site demonstration.
Tom McNally, National Sales Specialist, Wassenburg Medical, 07595 779 794.
CARINGNEWS 17
Advertiser’s announcement
All of homecare firm’s branches rated ‘outstanding’
ALL THREE of a homecare provider’s branches have been rated ‘outstanding’ overall by the Care Quality Commission.
It follows the first inspection of Westmorland Homecare’s Lancaster and Morecambe branch.
The CQC assessed the branch, which became operational in September 2020, on five key areas – whether the service was safe, effective, caring, responsive and well-led. The overall rating was ‘outstanding’.
Westmorland Homecare’s South Lakes branch – which is based in Kendal with a satellite office in Grange-over-Sands – and its Poulton, Fylde and Wyre branch are already rated ‘outstanding’ overall.
“It is absolutely fantastic that in the five years of setting up Westmorland Homecare we are achieving what we set out to do – providing one of the country’s leading homecare services,”
said Dr Chris Moss, one of the three directors of Westmorland Homecare Limited.
“We are one of the very few companies to have all of its branches rated outstanding by the CQC. It is testimony to the dedication of our

teams to providing a very special level of care, so that people can live life to the full. Whatever their age or ability we aim to allow people to remain at home, happy and peaceful.”
The Lancaster and Morecambe branch employs more than 50 staff, including homecare assistants. It operates in the Lancaster, Morecambe and surrounding areas, including Bolton-le-Sands and Carnforth.
Registered manager Dan Stainer said staff were ‘absolutely ecstatic’ with the CQC rating. “
It is a real reflection of all the outstanding work our carers provide,” he added.
Dan highlighted a specific case where staff had gone ‘over and above’ to look after a client.
“About a year ago there were power outages around Lancaster and we have a bedbound client with very complex needs who
lives alone. She has an electric bed and uses assistance technology to communicate with the outside world.
“We recognised she would be vulnerable so the on-call care co-ordinator went to her home with an electrical contractor, who installed a stand-alone generator to ensure she had power and heating.
“The lady was a little surprised when they arrived as she had not called them but she was over the moon by how far we went to make sure she was safe.”
The CQC report highlighted how Westmorland Homecare had enabled a client, who was aged over 100, to attend her niece’s wedding, accompanied by her favourite homecare assistant in the staff member’s own time.
In its overall summary the CQC stated: ‘People were receiving care from exceptionally caring staff that provided continuity of support.’
New Christmas specials from apetito
WITH Christmas just around the corner, care home meals provider apetito has been working hard to create the perfect festive menu to ensure residents can enjoy all their festive favourites and more –whatever their dietary requirements.
Developed by apetito’s team of in-house chefs and dietitians, the newly launched Christmas range includes festive treats such as Salmon en Croute Parcels, Brie and Cranberry Turnovers, Curried Parsnip Soup and Mincemeat Bars, all of which join apetito’s current classics such as Roast Turkey with Pigs in Blankets and Christmas Pudding.

It’s also never been easier for residents with dysphagia to be part of the festivities, thanks to apetito’s texture modified range of Level 4, 5 and 6, which includes delicacies such as Pureed Festive Pudding, as well as Sticky Toffee Pudding.
Richard Woodward, general manager of apetito’s care homes’ division said: “We know that Christmas is one of the most loved times of the year and we want residents to be able to enjoy the taste of Christmas.
“That’s why we are excited to be able to offer our new festive dishes alongside the traditional favourites that we know residents love.
“We’ve worked hard to ensure there is something for every care home resident in our Christmas range.
“Whether that is our Level 4 Pureed Festive Pudding or our Brie and Cranberry Turnovers and Mincemeat Bars which are packed with the flavours of Christmas and are a perfect addition to a care home Christmas party or Boxing Day buffet.”
Find out more about apetito’s care home service at https://www.apetito.co.uk/ourservice/care-home-meal-services.html
Can your care home do more for the environment?
MORE than six out of 10 people in the UK think care homes can act more sustainably when it comes to their kitchens and their cleaning – citing the use of recyclable packaging, less plastic, less toxic materials, less waste, and mobilising renewable energy, as coming top of their wish list.
A study of 2,000 adults by British cleaning chemical brand, Delphis Eco, found 76 per cent of people felt sustainability and climate change were very important to them.
But it also emerged 56 per cent of us feel too many businesses – including care homes – are ‘greenwashing’ for marketing purposes rather than in a concerted effort to make a real difference to the planet.
Many people felt the motives for becoming more sustainable were self-serving, with companies wanting to be seen as ‘doing their bit’ (39 per cent) and wanting to be seen as a ‘market leader’ (34 per cent) ranking among the top reasons for appearing sustainable.
A third felt that businesses wanting to save money in the long run, was
a factor for being more sustainable, compared to just 26 per cent who think it’s due to a real desire to help the planet.
Mark Jankovich, CEO of Delphis Eco, which commissioned the study, said: “Care homes can only buy what is available to them, so it’s important
we give them options and help them understand how making the right purchasing decisions can help their own environmental pedigree and help reduce their carbon emissions.
“Clearly, front line care is enormously important to care homes and the chemicals they use within the home – whether in the kitchen or general housekeeping must do the job in hand. But they don’t need to be toxic. It’s clearly important to residents and their families that homes do business in the right way and this aspiration can only become stronger alongside the headlines we see linked to climate change and the erosion of our planet’s resources.
“It’s easy for larger care groups and suppliers to focus on direct carbon emissions, which they can influence (or offset) more easily within their sites, but scope 3 emissions – which includes those indirect elements of the supply chain such as third-party cleaning chemicals and what they are using in the kitchen – should also be considered an important factor.
“We want to make sure we are
doing all we can, by ensuring we’re leading by example. Our cleaning chemicals are non-toxic, plantbased ingredients, yet they are extraordinarily powerful and do an exceptional job. All our packaging is made from 100 per cent recycled plastic, and we offer refills. We feel it’s the right way of doing business.
“We would urge homes to ask the question of their professional cleaning teams – what products are they using? Do they support their environmental targets and aspiration?.”
The research also found 55 per cent think every individual’s actions have an impact on the planet and they feel suppliers and businesses have a big responsibility to ensure that their actions really do make a difference when it comes to protecting the planet.
Mark added: “It’s encouraging to see just how important and valued most people are when it comes to our planet and increasingly, the need to protect our resources is being driven by the public mood.”

CARINGNEWS 18
Mark Jankovich
Bedroom, bathroom and beyond: the cutting edge of fall prevention
FALLS management remains a core challenge for care homes, especially due to the ongoing staffing crisis that often means longer periods between room checks.
That’s why demand is growing for a smarter approach to risk assessment and mitigation.
Caregivers need instant alerts on not only the major falls that cause injury but also the minor falls that so often lead to more serious incidents, but which often go unreported.
Some people forget, others don’t want to worry a loved one, and many are concerned about losing more of their independence and dignity, leaving caregivers in the dark about what’s really going on.
Care providers need to understand when, where and why residents are most likely to fall, how activity in different areas of their living spaces is connected, how it affects overall fall risk, and how to prevent falls.

They need to focus not only on the two main danger zones – the bedroom and the bathroom – but also on activity outside these areas.
Bedroom
Disturbed sleep is a significant fall risk factor.
As well as causing fatigue and dizziness, it’s associated with cognitive and functional impairment.
Monitoring sleep duration and quality is therefore essential to effective falls management.
After a night of interrupted sleep, a resident is at particularly high risk of falling when getting out of bed.
That’s why most care homes rely on bed pads and floor mats to provide alerts at these critical moments.
There are, however, several downsides. Such devices are often prone to triggering false alerts and have to be regularly replaced. What’s more, dementia sufferers may see floor mats as obstacles to be avoided, increasing fall risk.
Bathroom
Hard surfaces and water can be a lethal combination.
More than 80 per cent of elderly falls happen in bathrooms, and they’re twice as likely to result in injury as those in a living room.
Caregivers need instant, accurate fall detection that works even in the
high humidity of a steamy bathroom.
They also need to know if someone has lost consciousness in a shower seat or on the toilet, with an alert telling them that the resident has been in the bathroom for an unusually prolonged period.
Frequent bathroom visits are also linked to higher fall risk. Incontinence can cause an older adult to rush to the bathroom. Paired with low nighttime visibility, the likelihood of falling dramatically increases.
Beyond
Monitoring activity throughout a resident’s living space is also crucial to fall prevention.
Reduced mobility causes muscle wastage, making a fall much more likely. It can also be symptomatic of depression, which directly impacts fall risk.
Psychomotor retardation leads to slower thinking and movement due to decreased blood flow in parts of the brain and faulty dopaminergic neurotransmission, affecting balance.
Older adults with depression are at far higher risk of falling. One study estimates a 55 per cent increase for people with two risk factors and a 144 per cent rise for those with three or four.

That’s why it’s vital for caregivers to have access to analysis of behavioural data gathered over time.
Identifying significant changes is the key to true fall prevention.
Why privacy is paramount
When it comes to remote monitoring, privacy is essential.
Camera-based platforms have seen some success, but they’re widely seen as a less-than-ideal solution.
They often struggle in low lighting and humid conditions – precisely when residents need reliable fall detection.
They’re also highly invasive. Most older people are highly reluctant to allow cameras in their most personal spaces - the bedroom and bathroom.

In the words of Sandra Cooke, consultant at care home operator The Heidi Group: “The option of using cameras is a non-starter…. it’s totally against people’s human rights and privacy.”
Acoustic monitoring, meanwhile, can be perceived as equally intrusive. And while it can deliver accurate monitoring at night, it frequently fails to perform optimally during the day, when there’s more background noise.
RF imaging in care
Radio frequency (RF) imaging has recently emerged as a leading tech nology for fall detection and activity monitoring.
The data gathered by RF sensors is processed into point cloud imaging,
not visual images, safeguarding resident privacy. That data includes room presence, bed exits, and sleep duration, as well as bathroom visit times, frequency and duration.
Analysis of the data allows caregivers to identify at-risk residents and deliver personalised falls management and prevention.
Vayyar Care
Vayyar Care is your virtual caregiver in every room, delivering instant fall detection with industry-leading, camera-free accuracy.
Touchless sensors provide 24/7 visibility in all conditions, while maintaining privacy at all times.
Interoperable with any nurse call system and care platform, they also gather data that reveals symptoms of physical problems such as reduced mobility and UTIs, as well as mental health issues including depression, empowering predictive care and reducing staff workload.
It also supports imminent bed exit alerts, giving caregivers a window of opportunity to step in and prevent potential falls.
Vayyar Care is ushering in a new paradigm of proactive, preventative care.
To learn more about how you can leverage RF-based monitoring to enhance health and operational outcomes, visit vayyar.com/care/b2b
19 CARINGNEWS Advertiser’s announcement

Home to be named after late Prince Philip

RMBI Care Co. has recently completed and opened its new care home in Berkshire, which replaces the former Lord Harris Court, set in the same grounds.

The new home, Prince Philip Duke of Edinburgh Court, provides care and support for up to 45 people and offers nursing care and dementia support.
The environment has a contemporary feel and includes the latest assistive technologies and design, ensuring a personalised approach to support the residents.

Residents can now enjoy a variety of communal rooms, including café bar, lounges, dining rooms, private dining and hair salon. The spaces have been designed to make maximum use of light, and many rooms have easy access to garden or balconies for residents and their loved ones to enjoy the chancing view of the outdoors.
Home manager Abigail Cranston said: “The home has a wonderful, calm, homely feel. The residents are enjoying smaller communal spaces, which enable them to build closer connections.




“The new bistro area has been extremely popular with residents and relatives, all spending quality time together, enjoying activities and socialising.”
Staff at the CQC ‘Good’ rated facility















have been undertaking additional dementia training to help familiarise themselves with the new home.











John Boyington CBE, chairman of Trustees at RMBI Care Co., added: “This new state-of-the-art home has been our biggest investment in 15 years. As it has been specifically designed to meet the needs of older people looking for either nursing care or residential dementia support, it is a much welcomed addition to our portfolio.”
The naming of the new care home after the late Duke of Edinburgh, himself a Freemason for more than 60 years, adds to the charity’s group of Homes with royal names: Queen Elizabeth Court, in Llandudno; Prince George Duke of Kent Court, in Kent; Prince Michael of Kent Court, in Watford; Prince Edward Duke of Kent Court, in Braintree; and Albert Edward Prince of Wales Court, in Porthcawl.


21 OMMERCE Proper ty, finance, insurance, training & recruitment 07920 475 440 Office@lamontjohnson.com lamontjohnson .com SELLING CARE HOMES NATIONWIDE LOOKING FOR A DISCREET SALE? PHONE FOR A FREE NO OBLIGATION APPRAISAL Totally Confidential No Obligation LAMONT TO THE CARE SECTOR PROPERTY ADVISORS JohnsonLamont To our many clients from everyone at Lamont Johnson Merry Christmasand a happy and prosperous New Year Our success in the sale of Care Homes has been achieved through the 41 years experience of principal directors, Grayson and Dawn Taylor, and is second to none in the care sector. We specialise solely in the discreet sale and acquisition of Care Homes and sites/developments for C2 use nationwide. OVER 40 YEARS EXPERIENCE SELLING CARE HOMES NATIONWIDE m.07920 475 440 01937 842 758 Office@lamontjohnson.com lamontjohnson.com
Prince Philip Duke of Edinburgh Court in Berkshire.
Last chance saloon for social care ...
AS THIS issue goes to press, we are just days away from a critical Autumn Statement for the Government and for the country.
The Chancellor is under siege from all corners to announce measures that will get the economy back on track whilst also being warned that the statement is the ‘last chance to save the NHS’.
It is probably the last chance to save social care too.
The system isn’t working and there are reports that up to one in three hospital beds in some parts of England are occupied by people well enough to be discharged. Because there are no social care packages available, they remain in hospital, innocently contributing to the gridlock in the system identified by the Care Quality Commission.
The Health and Social Care Levy, funded through an increase in National Insurance, has been scrapped. At the same time, reform aimed at helping people meet the cost of care has also been kicked down the road once again.
The changes, including a more generous means-test and a lifetime cap on care costs of £86,000, were due to come into effect in October next year but there are reports that Number 10 and the Treasury are now proposing to delay the reform by a further two years, to 2025.
It is predicted that the Chancellor might allow local authorities to increase Council Tax to get more money into social care. Any extra funding would be welcome but
New home gets the green light
ROTHERWOOD Group has obtained planning permission to construct a purpose-built luxury care home in Colwall, Herefordshire.
Nestled on the western side of the Malvern Hills, on the border of Herefordshire and Worcestershire, the build will be located on a brownfield site.
It will provide 60 residential and nursing beds to support the demand for care in the region with its ageing population, whilst creating approximately 50 jobs in the local area. Work on the build is due to start by early 2023 with the view to opening in Spring 2024.
John Fennell, chief executive officer of Rotherwood, said: “We are thrilled to reveal plans for this luxury care home in Colwall. This will be our ninth care home in the group and will broaden our longterm impact enriching the lives of older people across the West Midlands.”
The build is funded through Target Healthcare and will be constructed by LNC Property Developments.
Designed by Lawrence and Finley Architects, the home will offer state-of-art facilities whilst its architectural features will echo that of Rotherwood’s other purposebuilt care home, Roden Hall, in Shropshire.
raising money in this way falls disproportionately unfairly on those living in poorer areas. And in any case, the sums involved would be a small sticking plaster when major surgery is required.
The Italian footballer, Mario Balotelli famously wore a t-shirt under his Manchester City top bearing the words, ‘Why Always Me?’ In social care, we know how he felt.
Balotelli used the words to ask why he was singled out as the bad boy of football, whereas social care is instead the innocent victim of endless cutbacks and, let’s face it, broken promises.
It is always social care that misses out.
Yes, financial storm clouds are gathering and the Government faces filling a £60bn black hole to get the economy back on track. But let’s face it, social care never got its fair share of funding even when the sun was shining more favourably on the country’s finances.
As a country, we failed to mend the roof on services like social care and now the place is sinking.
Thousands who benefit from social care and those who provide it have been very patient for reform and better funding.
For more than 30 years we have been calling for a better deal. In 1997, Tony Blair promised reform because he didn’t want children growing up in a country where people had to sell their home to pay for care.
Sadly, children born in 1997 are now 25 and they have grown up in a
country where far too many people do have to sell their home to get the care they need.
This week we have seen ambulances queuing outside Scarborough Hospital, presumably because of a shortage of beds inside. And one of the main reasons behind this is a lack of social care in the community to enable people to be discharged from those beds.
Thirty years of hurt for social care has left it in crisis, with Covid-19, chronic staff shortages and the costof-living situation turning things critical. Care and nursing homes are closing and homecare providers struggling through a lack of staff. There are 165,000 job vacancies in the sector.
We can end that gridlock with more funding for the sector so that we can pay our staff properly which would in turn help us to recruit more staff to provide the care that is needed.
People are taking to the street to protest about climate change and mothers are marching to demand better childcare provision.
But I am yet to see similar demonstrations over the crisis in the funding of social care for our most vulnerable adults.
And yet, a louder public voice seems likely to be the only way change will come. We need people to lobby their local MP to tell them that enough is enough and care of the vulnerable must be made a priority, whatever the state of the public finances.
Apparently, the cost of introducing the care cap would not be that great,
approaching some £2bn by 2026/27. And surely retaining it would be a popular decision with the voters.
But sadly, we do need more than the cap if we are to keep meeting the needs of the hundreds of thousands of people who rely on care and make inroads into the 1.6m who currently can’t get care.
We need to see proper investment and the Chancellor knows that. It was, after all, Mr Hunt who said, when he was Chair of the Health and Social Care Committee, that social care needed an extra £7bn a year just to stand still. He said then that the £7bn would be “a starting point for a wider series of reforms”.
Rather than shift responsibility onto local authorities and hard-pressed council tax payers, the Government should make a firm commitment to social care of at least that £7bn, funded through taxation as part of its measures to solve the crisis in NHS and social care.
If nothing happens, the cap is delayed and no significant additional funding for social care is forthcoming then the Government will have broken a 2019 manifesto promise and betrayed a generation of people who need care.
That is surely wrong and surely something that, as a country, we should be making more noise about. Yes, things change, but on something as important as the quality-oflife vulnerable people can enjoy, politicians should not make promises they cannot keep, and they must be reminded of that.
Home utilises family values to encourage others to join sector
A SCOTTISH home has championed family values as a means for others to consider a career in social care – with an array of inspiring carers taking the spotlight to share why there is no better time to join the sector.
Balquhidder House, a family-run care home in West Dunbartonshire and part of the Handsale care group, is shining a light on several of its carers and showcasing that there are an array of transferable skills that can be utilised in a career in social care –during a period where more people appreciate the importance of the role.
Amongst a shining example of selfless individuals, Balquhidder House has championed two carers and the contribution they make to the sector and their local communities.
The current focus is on highlighting the many transferable skills that come with a career in care, which 32-yearold carer Christine Aitken believes come in abundance.

“I’ve been working in social care for one-and-a-half years now and in that short space of time I’ve learnt and developed so many important skills,” said Christine, who is wellbeing facilitator at Balquhidder House.
“It’s the most rewarding job I’ve ever had. My previous background was in retail and cleaning, but I’ve
really found my feet here and I couldn’t be happier. I genuinely feel this is where I’m supposed to be and what I’m supposed to be doing. There’s no greater feeling than putting a smile on someone’s face.”
Christine’s sister, 37-year-old Gemma Gallagher, who is also a senior carer at Balquhidder, added: “I can’t think of a more rewarding and inspiring place to work. I’ve been at Balquhidder for four years now and the support system here has been incredible.
“Working alongside my sister helps, too. The benefits of working together with your family in care are that there is always someone there who understands you and helps you. I always have someone that can relate to how I’m feeling and can act as a support system in the most challenging times.”
Despite thriving together in their new environment, Christine and Gemma had a different relationship growing up and weren’t always the closest of siblings.
22
Christine Aitken and her sister Gemma Gallagher.
In his latest in a series of regular columns, care provider Mike Padgham, who is chair of the Independent Care Group, gives us his personal take on the big issues facing social care.
New luxury care home opens in Otley
TELEVISION presenter Martin Roberts was joined by the Town Mayor of Otley, Councillor Linda Hoare, to officially opened the doors of Anchor’s Wharfeside care home.

Martin met with professionals from the local community for a special launch event. Anchor, England’s largest not-for-profit provider of housing and care for people living in later life, will be welcoming new residents to the newly built home in November.
The state-of-the-art care home offers person-centred residential and dementia care and is purpose built to provide a safe and comfortable environment for residents.
Set in luxurious surroundings, Wharfeside has 66 en-suite bedrooms and a wealth of on-site facilities including communal outdoor spaces, a coffee shop, bar area and hairdressing salon.
The TV presenter enjoyed a tour of the home after raising a glass to the care home and cutting the ribbon to mark its official opening alongside Rob Martin, Anchor’s managing director of care services.
Rob said: “We’re delighted to open this new high-quality care home. Located in beautiful surroundings while still being close to Otley’s town centre, Wharfeside is a welcome addition to the care provision in the area and with nearly 60 years of experience in care and housing, all of us at Anchor look forward to welcoming new residents to this magnificent space.”
“This exciting addition to our care home portfolio demonstrates we are progressing the growth strategy set out in our Business Plan to create more and better homes where people can love living in later life and to create more opportunities for people to find a fulfilling career working in the social care sector.”
To commemorate the opening of the new home, Leeds North West
The three-storey care home built by LNT using the latest energy
technology has an Energy Performance Certificate A rating.
More than 80 per cent of the roof
is covered in solar panels and onsite battery stores retain any spare energy produced. In addition, the home benefits from extensive ground source heat pump technology which provides hot water and heating and enables residents to benefit from underfloor heating and comfort air cooling technology.
Wharfeside care home will replace Anchor’s Teal Beck House care home and residents and colleagues will be moved to the new location.

Team leader Shelley Seghetti, who has worked at Teal Beck House for more than six years, added: “I fell in love with the home the minute I stepped inside the door.
“From the views, the beautiful rooms, the spacious communal areas, it’s amazing.
“I can’t wait for the residents and the rest of my colleagues to see it. I’m sure they will love it as much as I do.
“We’ve made lots of memories at Teal Beck House care home and I look forward to making many more in this wonderful space.”
Wharfeside is now recruiting for various positions, including care assistants and domestic and kitchen support, to join the established care team from Teal Beck House.
Every new colleague will receive comprehensive training and professional development opportunities and can expect all the support they need to make the most of their career. Anchor also offers a wealth of benefits designed to boost wellbeing and support colleagues.
Independent expertise, nationwide knowledge


23 When industry knowledge and wisdom are needed, when a discreet sale is desired, our clients choose DC Care to sell their healthcare business. SALES | ACQUISITIONS | APPRAISALS | CONSULTANCY 01937 849 268 www.dccare.co.uk sales@dccare.co.uk
specialist healthcare business agents
DC Care is delighted to confirm the sale of , an immaculately presented residential care home registered for a maximum of 24 residents, located in the
of Rhyl. SOLD
North Wales town
specialist healthcare business agents 20TH ANNIVERSARY
Bryn Estyn, Rhyl, North Wales - Reg 24
MP Alex Sobel recently planted a tree in the home’s garden with assistance from children from St Joseph’s Primary School and Oliver Boundy,Anchor’s executive director of development.
efficient
Martin Roberts cuts the ribbon to officially open Anchor’s Wharfeside care home with Rob Martin, Anchor’s managing director of care services.
Ensuring you choose the correct agent
By Alison Willoughby
IF YOU are considering selling your care business, there are many factors you need to consider to instruct the right agent.
Most vendors want to sell for the highest price achievable in the market within a realistic marketing period. A good agent will take time to understand your requirements before they confirm their marketing advice. In choosing an agent you should consider who is going to provide the best service and who is likely to achieve the best results.
Perhaps consider the following:
1. Are the firm specialists in the sector?
2. Do they offer the right local or national coverage to maximise the exposure of your business to the most appropriate buyers?
3. Does the agent have regional offices, or a call centre?
4. Look at the depth of the
company; are they simply agents or are they also RICS Registered Valuers carrying out detailed valuations on a daily basis? This professionalism will become obvious when discussing your property.

Once, you have set up a meeting, there are a further list of questions you need to ask to avoid potential pitfalls.
1. Is the agent asking you detailed questions regarding the business and accounts to fully understand and provide detailed and logical advice?
2. Has the agent explained and justified the advice being provided? Often overinflated and marketing advice is provided simply to get vendors onto contracts that will cost them money. If properly explained,
recommendations are logical and should help vendors avoid the easy temptation to simply chase the asking price, overlooking the agent’s ability to sell, based on experience and market knowledge.
3. Enquire whether the agent you are meeting will be your contact throughout the sale process. Too many agents are never seen again and the property is simply listed on a website and enquiries processed by people who have never seen your business.
4. Ask how long the agent has been involved in the healthcare market and how much experience they have.
5. You then need to discuss the agents’ terms of engagement. How long is the contract for? Is there a
withdrawal fee? How many weeks’ termination notice do you need to give? Are upfront marketing fees charged in addition to the fee?
Buying a business is a significant investment. In the same way, selling that business is of a similar importance, so take it seriously, do your research and make the right decision.
Above all make your decision with your eyes open about what the agent’s service really is and why they are giving the advice they are giving. Remember not to believe the hype – If it sounds too good to be true it almost certainly is.
n Alison Willoughby is the divisional director and head of healthcare at Fleurets.

Defined by honesty, integrity and outstanding client service, Fleurets offers a full portfolio of services across the healthcare sector. Similar to you, looking after people and their needs is at the very core of what we do, so if you would like a confidential discussion about your care business then contact us today.

24
07879 073 195 Alison.Willoughby@fleurets.com www.fleurets.com
LOOKING TO SELL YOUR CARE BUSINESS?
Advertiser’s announcement
Alison Willoughby
Group introduces flexible working to attract staff
MARIA Mallaband Care Group is forging an improved approach to flexible working by inviting prospective new permanent employees and bank colleagues to ‘consider hours that work for them’.
This innovative offer has been designed to open up work in care homes for a wider field of potential talent, enabling those with young children or other caring responsibilities, students, or people with second jobs, to take up roles in a way that suits them, whether they can only work school hours, night shifts, or just at weekends.
The approach from Maria Mallaband Care Group heralds a move away from the traditional fulltime and set shift patterns of the past, to optional set weekly hours, part time contracts, and flexible bank opportunities, as well as flexible contracted hours.
Contracts can range from zero hours up to 40 hours per week. The scheme, being piloted nationally for new hires across England, will mean candidates can come to the recruitment process with the hours they want to work in mind, and each home will work to accommodate them if possible.
In addition, MMCG is looking to expand its roster of bank employees, giving them complete flexibility to pick up shifts week by week, whilst still gaining from the same full package of benefits as employees with contracted hours.
This is being rolled out across all of the group’s homes.
Laura Finlay, group head of talent acquisition, said: “Our flexible working initiative has been designed to welcome even more people into jobs within the care sector.

“We recognised that jobs in care can be inaccessible for parents with young children, those with other work and life commitments, and people who may only be looking for a parttime position.
“So, we have put aside the traditional approach with all its limitations, and created our unique MMCG way, focussed on meeting the needs of our staff, so that they can fulfil their passion for caring for others, without compromising their other commitments.”
The package of benefits at MMCG includes a welcome bonus of up to £1,500 for some homes, and a ‘refer a friend’ scheme which could see recipients gaining up to £1,500, along with EarlyPay, which gives staff the option to access some of their salary ahead of payday.
They can also take advantage of a Simply Healthcare scheme, which includes a wellbeing package and pension plan enrolment. There is the Cycle 2 Work and Fuel & Go Car Lease Scheme, both available through salary sacrifice.
In addition, team members can access a range of discounts and free monthly offers for a variety of high street shops and restaurants.
Fully funded training support and development opportunities are open to all employees, and there are rewards for years of service and annual staff recognition through MMCG Care Awards, along with a social events calendar.
The operator also covers the annual Nursing and Midwifery Council registration fee for nurses among the team (subject to conditions being met).
Anchor acquires Halcyon Care Homes Topco Limited
ANCHOR has completed its deal to acquire the entire share capital of Halcyon Care Homes Topco Limited.
The 11 purpose-built residential care homes, one of which is currently in development, are located in the East Midlands and the South of England – and brings the total number of care homes operated by the operator to 125.
The acquisition is a key part of Anchor’s Business Plan to have more and better homes where people love living in later life.
Anchor chief executive Sarah Jones said: “Our Business Plan details a clear strategy of growth.
“The addition of these purpose-built homes – and the skilled teams who work in them and within the support functions – enable us to bring the Anchor brand of high-quality, person-
centred care to a greater range of areas across England.
“Our two organisations have much in common in terms of organisational values and a commitment to innovate and continually improve our services to older people.
“I’m therefore very pleased to welcome the homes’ residents and colleagues to the Anchor family.”
The deal substantially increases Anchor’s care home estate and is the biggest care home acquisition by the group in recent years, following the purchase of 24 care homes from LNT Group and five care homes from Cavendish Healthcare Group seven years ago.
Five homes were also acquired from Hadrian Healthcare Group in 2019, with a further two expected to complete in 2023 and 2024.


Family-run operator completes acquisition of Essex care home
FAMILY-run care group Stow Healthcare has completed its latest acquisition of Great Horkesley Manor near Colchester in Essex.
The residential and dementia care home, purchased from care group provider Larchwood Care, is registered for 73 residents.

Owned and managed by brother and sister Roger Catchpole and Ruth French, Great Horkesley Manor is the eighth home to join the national award-winning care provider.
Roger said: “We are delighted to announce the acquisition of Great Horkesley Manor Care Home from

Larchwood Care. Stow Healthcare strives to be the premier residential, nursing, and memory care provider in the East of England.
“Stow Healthcare is excited to welcome Great Horkesley Manor to our group. As we move through the next phase, we look forward to getting to know residents, staff, and families.
“With the support of Essex County Council, the Care Quality Commission, and the local community, I am confident that we can turn Great Horkesley Manor into one of the best care homes in the area.”
•
•
•
•
•
25 Closed Former Care Home For Care/Community use onlyHarrogate
28 bedrooms - 16 with provision for en-suite WC & WHB
Traditional period building
Close to Harrogate Town Centre
Located opposite Valley Gardens/Pinewoods
Accommodation over four floors and loft Please call 01937 222107 or email enquiries@healthcarepc.co.uk FOR SALE: OFFERS INVITED www.healthcarepc.co.uk
Provider becomes an accredited Real Living Wage employer
ANCHOR, England’s largest not-forprofit provider of housing and care for older people, has become an accredited real Living Wage employer by the Living Wage Foundation.
The employer, which employs more than 9,000 colleagues across the country, is the largest care and housing provider, to achieve accreditation and commit to paying colleagues the real Living Wage for the foreseeable future, following an annual pay review each spring – which is higher than the National Minimum Wage.
The news comes as research by the Living Wage Foundation and Smith Institute, shows that if a quarter of those earning below the Living Wage saw their pay rise to the real Living Wage, the increase in wages, productivity and spending would deliver £1.8billion back in the UK economy.
The report, Local Living Wage Dividend, also shows that regions across the UK would see a significant economic boost if a quarter of lowpaid workers were uplifted to the real Living Wage. London would see the biggest boost (£208mn).
Followed by South-East (£197m), North-West (£190m), Yorkshire and the Humber (£165m) and West Midlands (£147m).
said:
“We’re very proud to become an accredited real Living Wage employer by the Living Wage Foundation, which enshrines our commitment to ensuring that people working in the housing and social care sector are appropriately rewarded for their hard
work.
“We also hope it will attract more people to join the sector to ensure we continue to deliver high quality services for residents.”
“Last year, we believe we became the first large provider of care and housing to pay all our colleagues, whatever their age, at or above the
Living Wage Foundation’s real Living Wage rate.
“We are committed to providing competitive rates of pay, an excellent range of benefits and outstanding opportunities to develop careers in a hugely fulfilling sector.
“We’re proudly not-for-profit which means every penny we make can be reinvested for the benefit of our colleagues and the older people who live in our locations.”
Anchor has already been paying its staff the real Living Wage, moving from National Living Wage hourly rates on December 1, 2021 for all roles across all services across the country.
Anchor marked its accreditation as a real Living Wage employer with a plaque unveiling ceremony at its head office in Bradford, on the first day of Living Wage Week, the Living Wage Foundation’s annual celebration of the Living Wage movement.

Anchor has voluntarily given a firm long-term commitment to its staff that it will continue to recognise their contribution in delivering high quality services and sustaining those services.
This aims to ensure that staff are paid a wage that is fair and will support them through the cost-ofliving crisis.
What Makes a Care Business Successful?
Is it because of a ‘good’ or ‘outstanding’ rating from CQC? Is it because of high occupancy or high weekly hours? Or maybe it’s due to a healthy staff culture?
Most people who have run or managed a care business know that any one of these components by itself isn’t the answer.
You’ll understand that all the different parts of a care business such as compliance, care delivery, HR, marketing and finance, must function together seamlessly, to create success and balance for the long-term. The Care Ideals team have been in your shoes and know it as well.
Our unique and innovative One Stop Shop approach simultaneously addresses every aspect of your care business. It saves you time and makes your life easier, as you only have to deal with one supplier for all these many needs.
We work as your business partners and advisers, providing a tailored level of on-going business, operational and staff support. This ensures that your business is managed successfully, leaving you and your team to deliver exceptional care.
Don’t just take our word for it...
“David is probably one of the most hardworking people that I have met and I am confident he would be an asset to anyone who makes use of his consultancy services. I saw engaging David as a Business Consultant as an investment which for us has been hugely rewarding.”
“I have once again seen how David balances the many pressures and conflicting priorities that come with running a business. David continues to ensure he has all the information he needs prior to recommending considered and sustainable changes, so as to address quality and financial issues to his clients. He has the experience to skilfully balance the needs of residents and patients, the staff and the shareholders and owners”
“As well as the operational improvements that David has been involved in, he has helped to give the business the impetus required to move forward. David is committed to helping people achieve their full potential and his focus on quality client care is completely genuine.”
Providing the balance between good business and exceptional care
26
Please contact us to discuss how our One Stop Shop can help you. 0330 133 5720 | enquiries@careideals.com | www.careideals.com
Kate Smith, executive director of business services at Anchor,
Kate Smith, executive director of business services at Anchor, with Lenka Kitchen, care assistant at Anchor’s Mill View care home, Lord Mayor of Bradford Martin Love and Marina Ageyeva, Living Wage Foundation programme manager.
Provider receive funding boost to improve lives of its tenants
Group helps staff tackle the cost of living crisis
A HOUSING provider has been awarded funding that will get older tenants involved in shaping new digital services, enabling them to live as independently as possible.

A NORTH Yorkshire care provider is offering new and existing staff cheaper shopping as it tackles the cost-of-living crisis and recruits new staff.

Bield has successfully secured £75,000 from the TAPPI project (Technology for our Ageing Population: Panel for Innovation) which aims to improve the way technology is used across the housing and care sector.
Saint Cecilia’s Care Group has joined up with a local shop chain to provide vouchers and a discount card to help current staff and as an incentive to new recruits.

Manson House is a popular 3- bed and is set in the heart of the historic
The funding will enable Bield to work with tenants to test different devices, apps and systems across a variety of housing settings.
Saint Cecilia’s managing director Mike Padgham said: “Staff are our most important asset and we want to do everything we can to support them through the current cost of living crisis.”
Tenants will be given shared responsibility, alongside staff, to co-produce digital services to support their independent living.
The TAPPI project will be led by the Housing Learning and Improvement Network, the TEC Services Association and funded by the Dunhill Medical Trust over a 12-to-15-month period.
When new staff join the company they receive £250 worth of One Stop vouchers, whilst existing staff have received £100 worth. All staff receive a discount card to get 10 per cent off in any of the One Stop chain of 17 shops. Saint Cecilia’s hopes the shopping scheme will help it to find new staff during a recruitment crisis in social care.
to them.”
independent living apartments. Managing director Roger Catchpole said: “We are delighted to announce the sale of Manson House from the RABI charity to Stow Healthcare has now completed.

Bield is one of six providers across the UK, and the only one in Scotland, to be awarded this funding.
The company has also held recruitment roadshows in Scarborough and Whitby.
Cambridge – to quantify benefits from their work and share what they have learnt with the wider housing and care sector.
to people to join our wonderful team.”
Dr Lynne Douglas, CEO at Bield Housing and Care, said: “We are very excited to be the Scottish testbed for TAPPI.
“In common with other care providers, we are struggling to recruit staff,” Mike added. “We have launched a recruitment drive and hope our cost of living incentive will also help us to add to our workforce.”
“This has huge potential to shift thinking on how housing can be integral to new models of delivery in the integration agenda.
To spread the word, Saint Cecilia’s has wrapped a van with a recruitment message and also added the message to one of its minibuses.
“Most importantly, it will be delivered together with older people to improve the outcomes that matter
The other providers are Haringey Council, Platform Housing Group, Pobl Group, Southend Care and Wiltshire Council.
Each will receive between £65,000 and £75,000 from the total award sum of £440,000.
“We are really pleased to be working with One Stop to offer the vouchers and discount cards – it is great to have two local businesses supporting each other to get through challenging times for everyone,” Mike added.
“The vouchers and discount card provides some help for our existing staff with the current cost of living crisis, whilst adding an extra incentive
All of the providers will work with researchers from The Cambridge Centre for Housing and Planning Research – part of the University of
Tracey Howatt, director of customer experience at Bield Housing and Care, added: “This important funding will improve the lives of our tenants and enable us to integrate technology throughout our services.
“This will ensure that our customers can live as independently as possible, in homes that have been designed to suit their care and support requirements.”
Saint Cecilia’s has a nursing home, two care homes and a day care centre in Scarborough, a nursing home in Whitby and a care home in Pickering. It has already increased pay for its 200+ staff in recent months and regularly rewards its staff with gifts like food hampers. It previously ran a recruitment campaign to attract nursing staff by offering a car and a holiday as part of the package.
“Stow Healthcare strives to be the premier provider of residential and nursing care in the East of England and we are thrilled to carry on the good name of the home, and continue to invest in the building, the technology and our loyal staff, to ensure every resident has a wonderful experience with us.
“We are really excited to welcome Manson House to our Group at this key stage of our growth.”
Stow Healthcare worked closely with RABI in the months leading up to the sale, to provide a seamless transition for residents, staff and all those connected with the home.
Barchester’s Charitable Foundation has announced the appointment of a new trustee to its board. Shannon Cullen brings a wealth of experience from her current work in the operator’s Queens Manor Care Home in Edinburgh, and her voluntary work in the community. Established in 2000, the aim of Barchester’s Charitable Foundation is to help older people and adults living with a disability or mental health problems in local communities across the country. The charity provides grants to improve mobility and quality of life, and each year the Foundation distributes more than £150,000 to individuals, small community groups and charities across England, Scotland and Wales. Shannon joined Barchester in May 2021 as head of lifestyle and enrichment at Queens Manor and was quickly promoted to her current role of senior head of lifestyle and enrichment three months later.
2729 Elderly Residential Home Central Region SOLD ngacare.co.uk If you are looking to buy or sell a care home contact Nick Greaves on 07943 107 887 or email nick@ngacare.co.uk Your Business Is Our Priority
acquisition
Saint Cecilia’s Care Group director Aaron Padgham and deputy manager Steph Harbron with some of the shopping vouchers and the recruitment message vehicles.
Time capsules mark opening of independent living scheme

THE Abbeyfield South Downs Society has marked the official opening of its affordable rental development, Holdenhurst, by burying two time capsules.

Local MP Huw Merriman, accompanied by Holdenhurst residents, High Sherrif Jane King and Abbeyfield South Downs CEO Nolan Taylor, buried the capsule under the iconic Monkey Puzzle tree in front of the building.
It included items that illustrate what it is like to live in Heathfield in 2022, as well as the history of the building, donated by individuals and organisations from around the local community.
The Society invited schools, community groups, businesses and residents of the town to contribute content for the capsules, including
photography of Heathfield, drawings, poems, stories and videos from local schoolchildren, describing and illustrating what living in Heathfield means to them, as well as contributions from local societies and clubs.

The capsules also included coins, stamps, a shopping receipt, front pages of national and local papers published on the day they were sealed, as well as a soil sample taken from the grounds of Holdenhurst in an airtight vial. The time capsules are marked by a plaque and will be dug back up in 50 years’ time.
Nolan said: “We are extremely excited to bury the time capsules and have enjoyed working with the Heathfield community to ensure its contents are truly representative of what it is like living in this thriving
market town. After the last couple of years everyone has had, it has been a fun and positive focus to bring the community together even more.
“Holdenhurst has long been a part of the community and local people will continue to play an important role at the affordable housing scheme. We thought of no better way to commemorate this by burying a time capsule.
“Over many years the site has been a facility for older members of the community and in its most recent incarnation, Holdenhurst regularly hosted the local Age UK day centre lunches. We hope the new building will be similarly used by local community groups.”
The new development comprises 48 affordable rental apartments, offering enhanced sheltered housing in a
A CARE operator which has its roots in Moray has submitted plans for a new multi-million pound care home in Elgin.
Parklands Care Homes, which next year celebrates its 30th anniversary, is seeking planning permission in principle for a new care home on a gateway site next to the A96.
The new care home is expected to provide dozens of jobs for the area and boost the local supply chain.
The proposal is for a 40-bed, two storey care home with secure landscaped gardens next to the Eight Acres Hotel.
There would be ample parking for staff and visitors and a biomass facility would provide renewable energy.
The care home would comply with the Care Inspectorate’s new 2022 Design Guidelines.
These new guidelines significantly raise the bar in a number of areas, including the quality of accommodation for residents, standards for infection control and adaptability of accommodation in the event of future lockdowns.
The new Elgin facility would be Parklands’ sixth Moray care home. It currently has homes in Aberlour, Keith and three in Buckie.
Work could start next year, coinciding with Parklands’ 30th anniversary, once detailed planning consents have been secured.
care-enabled environment to anyone over 60.
Holdenhurst has been designed to attract tenants who want to live in a vibrant and like-minded community where active, independent living is at its heart, but with the option of additional services if required now or in the future.
A restaurant, café and bar, hairdressing salon and a wellbeing suite for exercise, activities and crafts are also on site for tenants to use, as well as accessible spaces for local groups to have a place to meet.
The burial was followed by a launch party for its tenants, members of the Heathfield community and those who have played a role in the development as well as the time capsule, featuring a performance from local entertainer Chris Jacobs.
Ron Taylor, managing director of Parklands, said: “We have been looking at Elgin as a possible location for a new care home for some time.
“There is certainly very strong demand for a purpose built, high quality care facility in the town and it seems fitting that we should mark our 30th anniversary by coming back to our Moray roots.
“The project is still in its infancy but assuming we are granted planning consent in principle, we will develop a more detailed plan for the site.
“It represents a significant investment in local care services by Parklands.”

Parklands is currently building a new 58 bed care home in Inverness which will form part of an integrated care hub for the city, comprising the care home, a later living village and affordable homes for key workers.
Parklands has 10 homes across Moray and the Highlands and employs around 700 people.
The company was launched in Buckie in 1993.

28
Abbeyfield South Downs chairman David Byrne, Trustee Malcolm Paris, Huw Merriman MP and Abbeyfield South Downs chief executive Nolan Taylor (left): Holdenhurst residents Bill Western and Christine Tobin pictured with the time capsules (right).
Operator plans expansion with multi-million pound plans A96 WEST ROAD Eight Acres Hotel SITE ENTRANCE Raised Enbankment BED CARE HOME VISITOR PARKING STAFF PARKING/ DELIVERIES SECURE GARDEN SECURE GARDEN MAIN ENTRANCE BIOMASS BINSTORE PROPOSED 40 BED CARE HOME, EIGHT ACRES, ELGIN INDICATIVE SITE PLAN 133-200 1:500 A2 SCALE SIZE Planform Architects accepts responsibility for this document only to the commissioning party and not to any other. Planform Architects N SCALE 1:500 0 10 25 50 (M)
Firm breaks ground on new luxury care home
EAST Midlands contractor Kori Construction has broken ground on a new care home development in Rayleigh, Essex in a contract worth £10m.
The business is bringing forward the 60-bedroom facility on behalf of Barchester Healthcare.

The care home is part of a wider plan for a new residential scheme which includes outline planning permission for up to 500 houses, as well as non-residential facilities.



Occupying a 0.44 hectare green field site, it will provide high quality living accommodation and care to elderly and frail residents, along with communal facilities, landscaped grounds and parking facilities for visitors.
Wayne Bedier, project manager for Kori Construction at Rayleigh, said: “We are delighted to be able to break ground and start work on this important development.

“Rayleigh is a very popular and attractive town and as a result, there is significant demand for residential care. As in common with all Barchester Healthcare care homes, this development will provide a high quality solution, helping meet that demand. Each bedroom will have its own private wet room and en-suite facilities, ensuring continued independent living for residents,
and the wings and floors have been designed to function autonomously from each other allowing isolation to take place in the event of a virus outbreak. This ensures that the care home will provide precisely the right balance of independent living and security, giving residents and their family members complete peace of mind.”
The three storey property will have a total internal area of 3,572m2
The design includes 15 ground floor bedrooms, 21 bedrooms on the first floor and 24 on the second floor.
Building materials include red multi brick walls with dark grey cladding, dark grey roof tiles and natural stone window sills.

The development was also designed with sustainability in mind, achieving a ‘very good’ BREEAM rating due to PV panels on the roof, and a target to reduce water usage on site by 25 per cent. There will also be four EV charging points in the car park which has a total of 24 spaces, including two disabled spaces.
The development was forecast to be completed by December 2023.
Not-for-profit care village operator Belong has appointed Andrew Shield as business manager for the organisation’s growing home care service, Belong at Home. In the new position, Andrew will be responsible for leading the expansion of the award-winning home care service, which provides bespoke support packages, including expert dementia care, for people living independently, in a Belong village apartment or in the wider community. Andrew has worked for Belong at Home since its inception more than a decade ago, beginning his career as a community support worker before progressing to become area manager of the organisation’s Warrington and Didsbury services. A particular focus of Andrew’s role will be on recruitment as Belong at Home looks to continue to extend the provision of services to include areas in new locations.

29 The specialist, independent broker supporting the healthcare sector Offering a personal service with the specific, individual needs of our clients always at the forefront of our approach. Rooted within 25 years, we specialise in building relationships rather than transactional advice. Covering all aspects of Healthcare including residential & nursing homes, adults with learning and physical disabilities, domiciliary care, mental health organisations and supporting living. We understand the complex nature of the acquisition and disposal of a healthcare business.
Lake view
The Cottage
Book a confidential phone call: https://tinyurl.com/montanecare T: 01257 460270 M: 07546932811 E: anthony.rae@montanecare.co.uk montanecare.co.uk SOLD SOLD SOLD SOLD SOLD
Flightcare Group
The
Knells Plas Bod Llwyd
KORI project manager Wayne Bedier, pre-construction director Tony Robinson, contracts manager David Beazley and founding director Steve Culbert with (Barchester project manager Andrew Williamson.
Specialist baths from Gainsborough - your worldclass choice, 100 per cent proudly built in Britain
GAINSBOROUGH Specialist
Bathrooms is a best of British business delivering an unsurpassed 360-degree service in accessible bathrooms and baths for care homes, hospitals and rehabilitation facilities. So, what makes this organisation so unique?
Gainsborough is no ordinary supplier. It has been a trusted, specialist bath manufacturer for more than 35 years with a highly established production line based in the West Midlands.
Its dedicated and diligent workforce handcraft power assisted bathing solutions here in the UK that are 100 per cent bather-centric – ensuring maximum safety and care for vulnerable users.
Add to this ultra efficiency, performance and ergonomics, healthcare providers who choose Gainsborough benefit from optimum safety, reduced risk and impressive economics.
Gainsborough is a truly British business leading the world in assistive bathing technology. Its R&D department is renowned for continually raising the bar in terms of bather comfort and carer support.

With one of the largest manufacturing facilities of its kind in Europe, Gainsborough represents the respected name in hi-lo baths with a range that meets all care needs.
From the reclining Sentes for added postural support to the multi-faceted, highly adaptable Gentona, every bath from Gainsborough enhances CQC excellence and provides outstanding capital expenditure ROI.

Despite continuing global supply chain issues, Gainsborough continues to deliver an exceptional British service:
n One of the fastest lead times for bath delivery.
n UK-built baths with high quality control (ISO 9001).
n Total support from design and install to servicing and warranty –UK-based team.
n UK family owned – delivering caring, ethical service with ‘British family values’ at the heart of the business.
n Baths crafted with British passion, pride and precision.
n Unique BioCote antimicrobial technology.
Alongside bath manufacturing, Gainsborough offers its G360 services for complete accessible bathroom and wet room provision.
This holistic service, from concept to completion, perfectly synergises with its bath supply and provides an unequalled level of support.
Every aspect is managed through Gainsborough so project delivery on time and within budget is assured.
Healthcare providers can now avoid the hassle of dealing with multiple
suppliers as G360 co-ordinates all bathroom works – ensuring client management time and resources are protected.
In summary and bearing in mind the global situation right now, choosing a highly creditable, established UK bath manufacturer represents the considered choice.
Why select a mere supplier or an organisation based abroad when Gainsborough offers all the homegrown quality you will ever need?
Gainsborough Specialist Bathrooms – your world-class choice, 100 per cent proudly built in Britain.
www.gainsboroughbaths.com
Spend 25 per cent less on products at Gompels
WE like to think of ourselves as more than just a supplier.
We will show you how to easily reduce your expenditure by 25 per cent and more.
All of our tools are completely free and already set up for you.
Save time, save money, and start profiting today with Gompels; a hassle-free supplier who looks after you for the long term.
n Business Dashboard typically
saves you five per cent from having actionable spend analysis.
n Budget alerts reduce overspend and save you a whopping seven per cent.
n With a smart core list in place for your sites, you can save 10 per cent on your purchasing.
Don’t just take our word for it…
“Gompels helped to streamline, not only the supply, but also the products
themselves by implementing a flexible fore list for the homes to order from.
“We were really impressed by Gompels consolidated invoicing, our finance team can simply log in and download the invoices, and can also see at a glance what is due.
“Gompels also offer direct debit which means the team does not have to spend time setting up payments.”
We do the basics brilliantly Since working with National Autistic Society since the pandemic began: n More than 2,500 orders have been placed.
n 99.64 per cent of orders arrived the next working day and in full.
ADL Care
Kelly Jackson, procurement director,
If you are a group customer and want to learn more, contact our key account manager Sam Paines by emailing sam.paines@gompels.co.uk or calling 0345 450 2420.
How to optimise laundry room efficiency at your care home
WITH care home providers facing soaring energy costs, Forbes Professional advises on how to optimise laundry room efficiency.
Facing unprecedented energy costs and an increasingly pressing climate crisis, care home operators are all aiming to minimise energy consumption.
According to the Carbon Trust, the care sector spends more than £400million on energy each year and after heating and lighting, it is irrefutable that appliances are a main contributor to this figure. For any care home, laundry is a key service area and one that is absolutely critical to maintaining infection control.
Thankfully, whereas you can’t turn down the heating in a care environment, or turn off the lighting, there are ways in which you can significantly reduce the energy consumed by your laundry function.
Forbes Professional helps care home operators source the most
energy, water and user efficient laundry solutions whilst advising on all relevant WRAS and industry requirements. When choosing dryers, it is notable that care homes are increasingly turning away from gas appliances due to increasing running costs and safety concerns.
This is all the more notable now that changes to industry requirements are necessitating considerable investment in order for gas appliances to meet the current standards. Forbes would generally recommend that electrical appliances should be the product of choice, with heat pump dryers enabling astounding cost and energy savings.
Miele’s new heat pump commercial dryers are particularly highly rated for their safety, functionality and energy efficiency. They employ a highly efficient and economical filter system and heat exchanger to keep run times low and enable an energy saving of up to 60 per cent when compared to
vented dryers.
Additionally, these heat pump dryers do not require any makeup air, which enables the laundry function to be installed in the basement or in a central location within the care-home and saves on costly vent-ducting.
Due to the effective interaction of the Miele filter system and the maintenance-free heat exchanger, fluff cannot clog the heat exchanger or adversely affect the exceptional drying efficiency.
With regards to washing machines, only a commercial washing machine will suffice in a care environment as only these machines will meet the WRAS requirements for Fluid Category 5.
Forbes recommends using Miele commercial washing machines as they are highly energy and water efficient whilst delivering both thermal and sluice disinfection.
As an illustrative example, based
on an electricity cost of £0.34/kWh and three machines being used four times/ day for five years, Miele machines can realise a running cost saving of £9,529 when compared to another industry brand.
Auto-dosing equipment also provides a great solution for ensuring that the right amount of detergent is dispensed for each cycle; minimising waste, optimising the wash cycle and saving both money and time.
Forbes Professional provides a range of options for commercial laundry equipment, including autodosing equipment as well as Miele commercial laundry machines.
All of their products are available on a purchase, rental or lease basis, with access to a comprehensive service that includes installation, commissioning, user-training and a multi award-winning repair and maintenance response.
Call 0345 0702335, email info@forbesprofessional.co.uk or visit forbespro.co.uk
CARINGPRODUCT NEWS 30











01527 400 022 info@gainsboroughbaths.com www.gainsboroughbaths.com ADVANCED CARE WITH SUSTAINED RELIABILITY ULTIMATE COST EFFICIENCY WITH PIONEERING HYGIENE AND SAFETY SENTES GENTONA A powered reclining bathing solution with enhanced postural support for more complex bather needs An ultra-efficient, world-class variable-height power assisted bath, with bather transfer seat and integrated antimicrobial protection • Easy one-touch tilt with hoisting access • Multiple safety and comfort features • Reduced operational costs • Impressive 205kg SWL • Redefining performance, long-term value and moving & handling excellence • Ultra-energy and water efficiency • Therapeutic options including Airspa, lighting and sound • Proven for advanced dementia care • Holistic lifetime servicing and LOLER testing © Gainsborough Healthcare Group. 10 & 11 The Oaks, Clews Road, Redditch, Worcestershire, B98 7ST. 01527 400 022 info@gainsboroughbaths.com www.gainsboroughbaths.com OUR PROTECTION PROMISE
SEASONS GREETINGS

call: 01924 868470 visit: shackletonsltd.co.uk